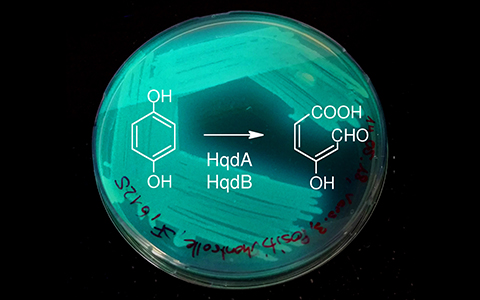

Umweltbiotechnologie
Der Einsatz von Mikroorganismen zu Gunsten der Umwelt.
Die Umweltbiotechnologie setzt Mikroorganismen und deren Enzyme ein, um das Potenzial biologischer Stoffwechselprozesse zu Gunsten der Umwelt nutzbar zu machen: Umweltschadstoffe sollen aus Abwässern und Altlasten beseitigt, natürliche Rohstoffreserven aus Abfällen effizient verwertet werden. Die Forschungsgruppe „Umweltbiotechnologie“ erprobt und entwickelt innovative Verfahren, um diese Ziele zu erreichen.
Wir arbeiten an Möglichkeiten, um die Emissionen von Schadstoffen zu vermindern und vorhandene Schadstoffe zu beseitigen. Ausserdem entwickeln wir Methoden zur Verwertung von Stoffen aus industriellem Prozesswasser, Abwasser und Abfällen. Auf diese Weise sollen – neben sparsamem Umgang mit nicht-erneuerbaren Ressourcen und dem verstärkten Einsatz nachwachsender Rohstoffe - geschlossene Stoffkreisläufe entstehen. Mit der Entwicklung neuer biobasierter Prozesse sowie der Anpassung und Weiterentwicklung herkömmlicher Technologien tragen wir zum Wohl der Umwelt und der Gesellschaft bei.